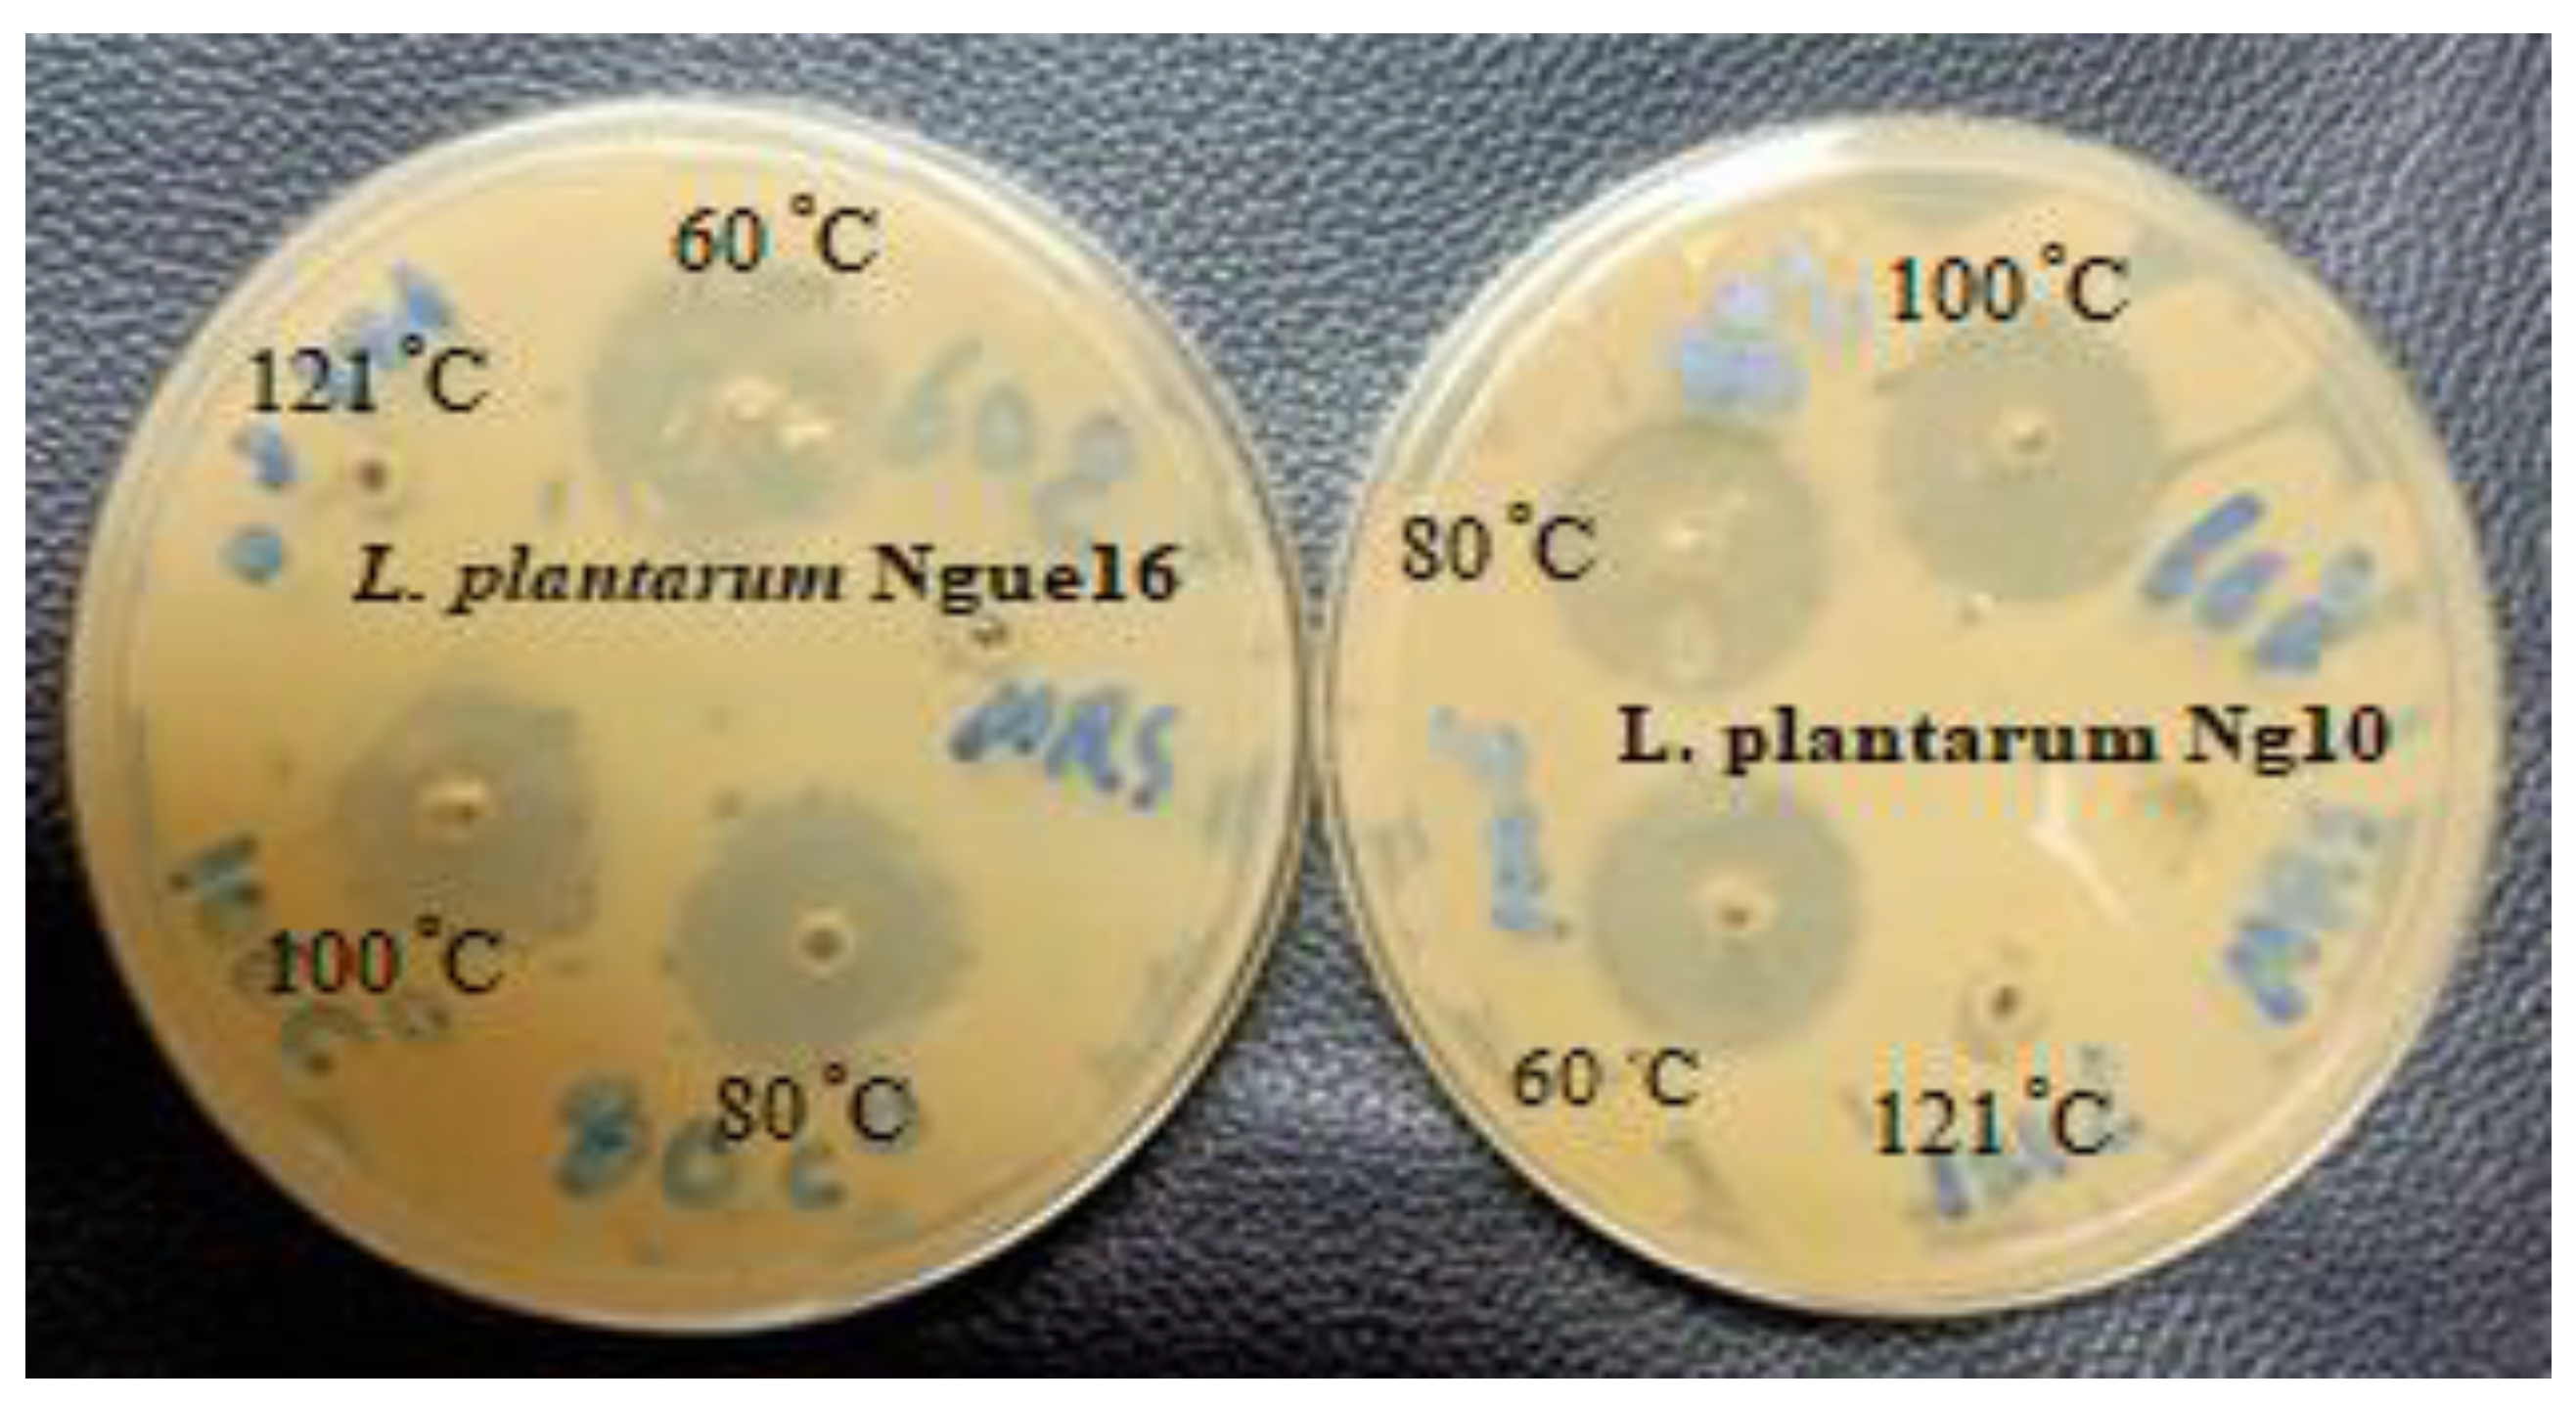
Metabolites 13 00849 g003
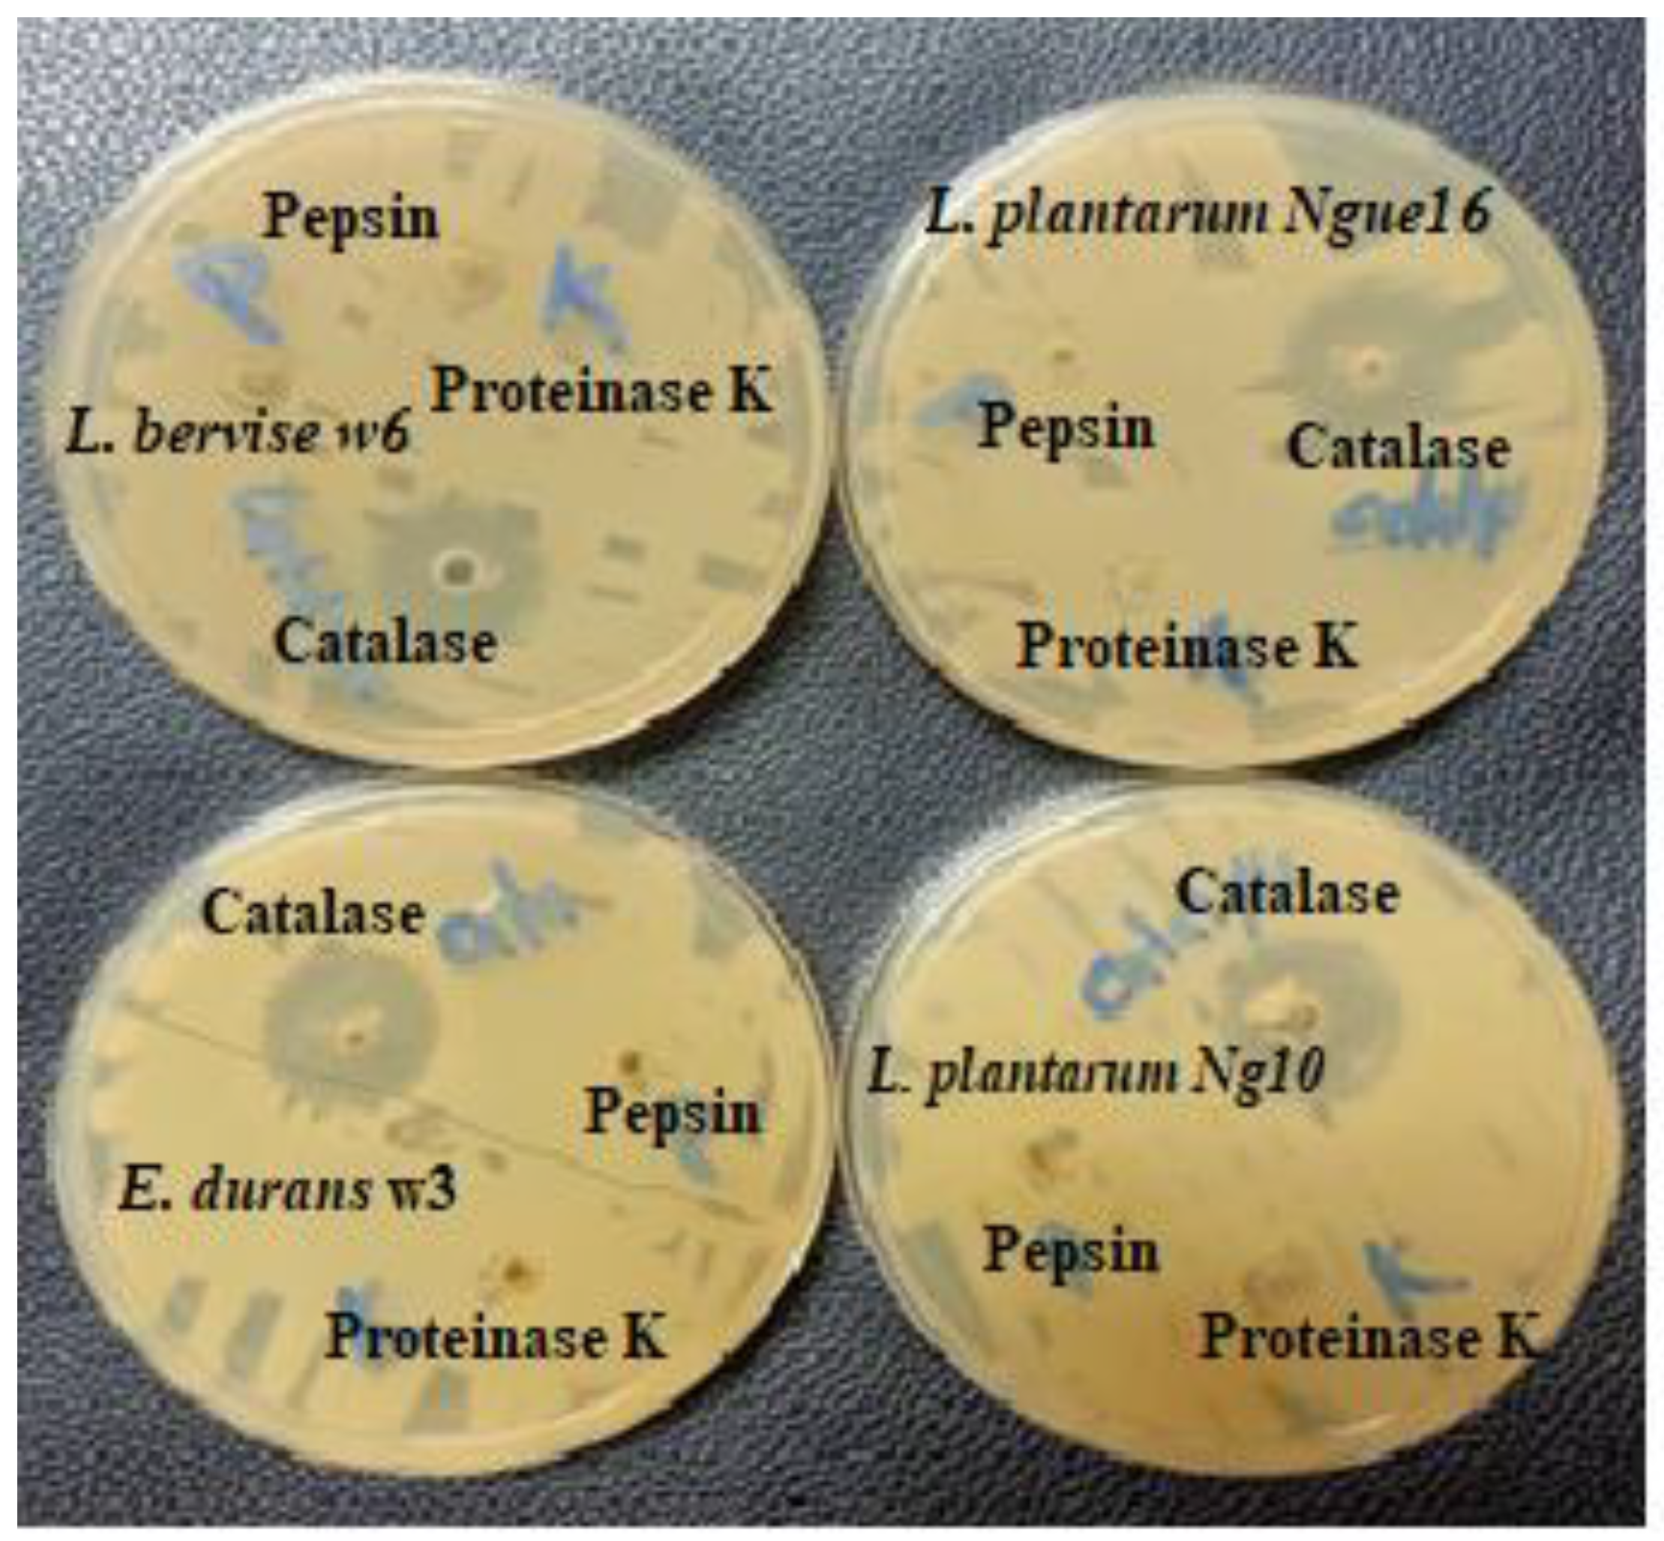
Metabolites 13 00849 g004

Biological Characterization and Metabolic Variations among Cell-Free Supernatants Produced by Selected Plant-Based Lactic Acid Bacteria
Abstract
1. Introduction
2. Materials and Methods
2.1. Bacterial Strains and Culture Conditions
2.2. Preparation of Cell-Free Supernatant from Lactic Acid Bacteria
2.3. Antibacterial Activity of Lactic Acid Bacterial Cell-Free Supernatant
2.3.1. Spot Assay
2.3.2. Well Diffusion Assay
2.3.3. Determination of Minimum Inhibitory Concentration and Minimal Bactericidal Concentration
2.4. Characterization of Antibacterial Compounds Produced by Lactic Acid Bacterial Strains
2.4.1. Effect of Heat Treatment and pH Adjustment on the Antibacterial Activity of Lactic Acid Bacterial Cell-Free Supernatant
2.4.2. Effect of Enzymes on Antibacterial Activity of Lactic Acid Bacterial Cell-Free Supernatant
2.5. Antioxidant Activity of Lactic Acid Bacterial Cell-Free Supernatant
2.5.1. DPPH Radical Scavenging Activity Assay
2.5.2. Ferric Reducing Antioxidant Power (FRAP) Assay
2.6. NMR Measurement and Data Pre-Processing
2.7. Statistical Analyses
3. Results and Discussion
3.1. Antibacterial Activity of LAB Cells and Cell-Free Supernatant
3.1.1. Spot Assay and Well Diffusion Method
3.1.2. Minimum Inhibitory Concentration and Minimal Bactericidal Concentration
3.2. Characterization of Antibacterial Compounds Produced by Lactic Acid Bacterial Strains
3.2.1. Effect of pH Adjustment and Heat Treatment on the Antibacterial Activity of Lactic Acid Bacterial Cell-Free Supernatant
3.2.2. Effect of Enzymes on the Antibacterial Activity of Lactic Acid Bacterial Cell-Free Supernatant
3.3. Antioxidant Activity of LAB Cell-Free Supernatant
3.4. Bioactive Metabolites of LAB Cell-Free Supernatant
4. Conclusions
Author Contributions
Funding
Institutional Review Board Statement
Informed Consent Statement
Data Availability Statement
Acknowledgments
Conflicts of Interest
References
- Adimpong, D.B.; Nielsen, D.S.; Sørensen, K.I.; Derkx, P.M.F.; Jespersen, L. Genotypic Characterization and Safety Assessment of Lactic Acid Bacteria from Indigenous African Fermented Food Products. BMC Microbiol. 2012, 12, 75. [Google Scholar] [CrossRef] [PubMed]
- Ouwehand, A.C.; Kirjavainen, P.V.; Shortt, C.; Salminen, S. Probiotics: Mechanisms and Established Effects. Int. Dairy J. 1999, 9, 43–52. [Google Scholar] [CrossRef]
- Husain, F.M.; Al-Shabib, N.A.A.; Alyousef, A.; Khan, A.; Arshad, M.; Hassan, I.; Albalawi, T.A.; Ahmad, I. Probiotic Bacteria Used in Food: A Novel Class of Antibiofilm Agent. In Functional Food Products and Sustainable Health; Springer: Berlin/Heidelberg, Germany, 2020; pp. 25–35. [Google Scholar]
- Ghaffar, T.; Irshad, M.; Anwar, Z.; Aqil, T.; Zulifqar, Z.; Tariq, A.; Kamran, M.; Ehsan, N.; Mehmood, S. Recent Trends in Lactic Acid Biotechnology: A Brief Review on Production to Purification. J. Radiat. Res. Appl. Sci. 2014, 7, 222–229. [Google Scholar] [CrossRef]
- Castellone, V.; Bancalari, E.; Rubert, J.; Gatti, M.; Neviani, E.; Bottari, B. Eating Fermented: Health Benefits of LAB-Fermented. Foods 2021, 10, 2639. [Google Scholar] [CrossRef] [PubMed]
- Sharma, R.; Garg, P.; Kumar, P.; Bhatia, S.K.; Kulshrestha, S. Microbial Fermentation and Its Role in Quality Improvement of Fermented Foods. Fermentation 2020, 6, 106. [Google Scholar] [CrossRef]
- Lazarus, R.P.; John, J.; Shanmugasundaram, E.; Rajan, A.K.; Thiagarajan, S.; Giri, S.; Babji, S.; Sarkar, R.; Kaliappan, P.S.; Venugopal, S. The Effect of Probiotics and Zinc Supplementation on the Immune Response to Oral Rotavirus Vaccine: A Randomized, Factorial Design, Placebo-Controlled Study among Indian Infants. Vaccine 2018, 36, 273–279. [Google Scholar] [CrossRef]
- Unban, K.; Chaichana, W.; Baipong, S.; Abdullahi, A.D.; Kanpiengjai, A.; Shetty, K.; Khanongnuch, C. Probiotic and Antioxidant Properties of Lactic Acid Bacteria Isolated from Indigenous Fermented Tea Leaves (Miang) of North Thailand and Promising Application in Synbiotic Formulation. Fermentation 2021, 7, 195. [Google Scholar] [CrossRef]
- Yang, J.; Wang, J.; Yang, K.; Liu, M.; Qi, Y.; Zhang, T.; Fan, M.; Wei, X. Antibacterial Activity of Selenium-Enriched Lactic Acid Bacteria against Common Food-Borne Pathogens in Vitro. J. Dairy Sci. 2018, 101, 1930–1942. [Google Scholar] [CrossRef]
- Nasri, N.; Harahap, U.; Silalahi, J.; Satria, D. Antibacterial Activity of Lactic Acid Bacteria Isolated from Dengke Naniura of Carp (Cyprinus carpio) against Diarrhea-Causing Pathogenic Bacteria. Biodiversitas J. Biol. Divers. 2021, 22, 3098–3104. [Google Scholar] [CrossRef]
- Mohamad, N.I.; Manan, M.A.; Sani, N.A. The Antibacterial Activity of Lactic Acid Bacteria from Pickled Spondias dulcis (Ambarella) against Foodborne Pathogens. Trends Sci. 2022, 19, 2896. [Google Scholar] [CrossRef]
- Lü, J.; Lin, P.H.; Yao, Q.; Chen, C. Chemical and Molecular Mechanisms of Antioxidants: Experimental Approaches and Model Systems. J. Cell. Mol. Med. 2010, 14, 840–860. [Google Scholar] [CrossRef] [PubMed]
- Luo, D.; Fang, B. Structural Identification of Ginseng Polysaccharides and Testing of Their Antioxidant Activities. Carbohydr. Polym. 2008, 72, 376–381. [Google Scholar] [CrossRef]
- Afify, A.E.-M.M.R.; Romeilah, R.M.; Sultan, S.I.M.; Hussein, M.M. Antioxidant Activity and Biological Evaluations of Probiotic Bacteria Strains. Int. J. Acad. Res. 2012, 4, 131–139. [Google Scholar] [CrossRef]
- Ou, C.-C.; Ko, J.-L.; Lin, M.-Y. Antioxidative Effects of Intracellular Extracts of Yogurt Bacteria on Lipid Peroxidation and Intestine 407 Cells. J. Food Drug Anal. 2006, 14, 10. [Google Scholar] [CrossRef]
- Shen, Q.; Shang, N.; Li, P. In Vitro and in Vivo Antioxidant Activity of Bifidobacterium Animalis 01 Isolated from Centenarians. Curr. Microbiol. 2011, 62, 1097–1103. [Google Scholar] [CrossRef]
- Zhang, Y.; Li, Y. Engineering the Antioxidative Properties of Lactic Acid Bacteria for Improving Its Robustness. Curr. Opin. Biotechnol. 2013, 24, 142–147. [Google Scholar] [CrossRef]
- Xia, C.; Tian, Q.; Kong, L.; Sun, X.; Shi, J.; Zeng, X.; Pan, D. Metabolomics Analysis for Nitrite Degradation by the Metabolites of Limosilactobacillus fermentum RC4. Foods 2022, 11, 1009. [Google Scholar] [CrossRef]
- Ozogul, F.; Tabanelli, G.; Toy, N.; Gardini, F. Impact of Cell-Free Supernatant of Lactic Acid Bacteria on Putrescine and Other Polyamine Formation by Foodborne Pathogens in Ornithine Decarboxylase Broth. J. Agric. Food Chem. 2015, 63, 5828–5835. [Google Scholar] [CrossRef]
- Kivanc, M.; Yilmaz, M.; Çakir, E. Isolation and Identification of Lactic Acid Bacteria from Boza, and Their Microbial Activity against Several Reporter Strains. Turk. J. Biol. 2011, 35, 313–324. [Google Scholar] [CrossRef]
- Darsanaki, R.K.; Rokhi, M.L.; Aliabadi, M.A.; Issazadeh, K. Antimicrobial Activities of Lactobacillus Strains Isolated from Fresh Vegetables. Middle-East J. Sci. Res. 2012, 11, 1216–1219. [Google Scholar]
- Sani, N.A.; Sawei, J.; Ratnam, W.; Rahman, Z.A. Physical, Antioxidant and Antibacterial Properties of Rice (Oryza sativa L.) and Glutinous Rice (Oryza sativa var. glutinosa) from Local Cultivators and Markets of Peninsular, Malaysia. Int. Food Res. J. 2018, 25, 2328–2336. [Google Scholar]
- Bajpai, V.K.; Rather, I.A.; Majumder, R.; Alshammari, F.H.; Nam, G.; Park, Y. Characterization and Antibacterial Mode of Action of Lactic Acid Bacterium Leuconostoc Mesenteroides HJ69 from Kimchi. J. Food Biochem. 2017, 41, e12290. [Google Scholar] [CrossRef]
- Muhialdin, B.J.; Hassan, Z.; Saari, N. In Vitro Antifungal Activity of Lactic Acid Bacteria Low Molecular Peptides against Spoilage Fungi of Bakery Products. Ann. Microbiol. 2018, 68, 557–567. [Google Scholar] [CrossRef]
- Lin, M.Y.; Chang, F.J. Antioxidative Effect of Intestinal Bacteria Bifidobacterium longum ATCC 15708 and Lactobacillus acidophilus ATCC 4356. Dig. Dis. Sc. 2000, 45, 1617–1622. [Google Scholar] [CrossRef]
- Musa, K.H.; Abdullah, A.; Jusoh, K.; Subramaniam, V. Antioxidant Activity of Pink-Flesh Guava (Psidium guajava L.): Effect of Extraction Techniques and Solvents. Food Anal. Methods 2011, 4, 100–107. [Google Scholar] [CrossRef]
- Abdusalam, K.B.; Yee, L.S.; Mediani, A.; Akhtar, M.T.; Buzgaia, N.; Rukayadi, Y.; Ismail, I.S.; Shaari, K. 1H NMR-Based Metabolomics Profiling of Syzygium Grande and Oenanthe Javanica and Relationship between Their Metabolite Compositions and Antimicrobial Activity against Bacillus Species. Rec. Nat. Prod. 2022, 16, 128–143. [Google Scholar]
- Balouiri, M.; Sadiki, M.; Ibnsouda, S.K. Methods for in Vitro Evaluating Antimicrobial Activity: A Review. J. Pharm. Anal. 2016, 6, 71–79. [Google Scholar] [CrossRef]
- Mohamad, N.I.; Manan, M.A.; Sani, N.A. Isolation and Identification of Lactic Acid Bacteria from Local Pickled Mango with Antibacterial Potential. AIP Conf. Proc. 2019, 2111, 050011. [Google Scholar]
- Aween, M.M.; Hassan, Z.; Muhialdin, B.J.; Eljamel, Y.A.; Al-Mabrok, A.S.W.; Lani, M.N. Antibacterial Activity of Lactobacillus acidophilus Strains Isolated from Honey Marketed in Malaysia against Selected Multiple Antibiotic Resistant (Mar) Gram-positive Bacteria. J. Food Sci. 2012, 77, M364–M371. [Google Scholar] [CrossRef]
- Shi, Y.; Cui, X.; Gu, S.; Yan, X.; Li, R.; Xia, S.; Chen, H.; Ge, J. Antioxidative and Probiotic Activities of Lactic Acid Bacteria Isolated from Traditional Artisanal Milk Cheese from Northeast China. Probiotics Antimicrob. Proteins 2019, 11, 1086–1099. [Google Scholar] [CrossRef]
- Sirichokchatchawan, W.; Pupa, P.; Praechansri, P.; Am-In, N.; Tanasupawat, S.; Sonthayanon, P.; Prapasarakul, N. Autochthonous Lactic Acid Bacteria Isolated from Pig Faeces in Thailand Show Probiotic Properties and Antibacterial Activity against Enteric Pathogenic Bacteria. Microb. Pathog. 2018, 119, 208–215. [Google Scholar] [CrossRef]
- Rozila, I.; Ezni, S.; Lani, M.N.; Sharina, M.D.; Siti, H.M.; Asma, H.; Sharida, M.D. Antibacterial Activity of Lactic Acid Bacteria Isolated from Goats’ Milk. In Proceedings of the International Annual Symposium on Sustainability Science and Management, Terengganu, Malaysia, 9–11 July 2012; pp. 9–11. [Google Scholar]
- Saleh, F.A. Isolation and Identification of Microorganisms and Antibacterial Activity of Laban Zeer, an Egyptian Traditional Fermented Milk Product. Sci. J. Microbiol. 2013, 2, 31–42. [Google Scholar]
- Ren, D.; Zhu, J.; Gong, S.; Liu, H.; Yu, H. Antimicrobial Characteristics of Lactic Acid Bacteria Isolated from Homemade Fermented Foods. Biomed Res. 2018, 2018, 5416725. [Google Scholar] [CrossRef]
- Ibrahim, S.A.; Ayivi, R.D.; Zimmerman, T.; Siddiqui, S.A.; Altemimi, A.B.; Fidan, H.; Esatbeyoglu, T.; Bakhshayesh, R.V. Lactic Acid Bacteria as Antimicrobial Agents: Food Safety and Microbial Food Spoilage Prevention. Foods 2021, 10, 3131. [Google Scholar] [CrossRef] [PubMed]
- Cui, X.; Shi, Y.; Gu, S.; Yan, X.; Chen, H.; Ge, J. Antibacterial and Antibiofilm Activity of Lactic Acid Bacteria Isolated from Traditional Artisanal Milk Cheese from Northeast China against Enteropathogenic Bacteria. Probiotics Antimicrob. Proteins 2018, 10, 601–610. [Google Scholar] [CrossRef] [PubMed]
- Kazemipoor, M.; Radzi, C.W.J.W.M.; Begum, K.; Yaze, I. Screening of Antibacterial Activity of Lactic Acid Bacteria Isolated from Fermented Vegetables against Food Borne Pathogens. arXiv 2012, arXiv:1206.6366. [Google Scholar]
- Daba, G.M.; Elkhateeb, W.A. Bacteriocins of Lactic Acid Bacteria as Biotechnological Tools in Food and Pharmaceuticals: Current Applications and Future Prospects. Biocatal. Agric. Biotechnol. 2020, 28, 101750. [Google Scholar] [CrossRef]
- Cizeikiene, D.; Juodeikiene, G.; Paskevicius, A.; Bartkiene, E. Antimicrobial Activity of Lactic Acid Bacteria against Pathogenic and Spoilage Microorganism Isolated from Food and Their Control in Wheat Bread. Food Control. 2013, 31, 539–545. [Google Scholar] [CrossRef]
- Bajpai, V.K.; Han, J.-H.; Rather, I.A.; Park, C.; Lim, J.; Paek, W.K.; Lee, J.S.; Yoon, J.-I.; Park, Y.-H. Characterization and Antibacterial Potential of Lactic Acid Bacterium Pediococcus pentosaceus 4I1 Isolated from Freshwater Fish Zacco koreanus. Front. Microbiol. 2016, 7, 2037. [Google Scholar] [CrossRef]
- Soundharrajan, I.; Kim, D.; Kuppusamy, P.; Muthusamy, K.; Lee, H.J.; Choi, K.C. Probiotic and Triticale Silage Fermentation Potential of Pediococcus pentosaceus and Lactobacillus brevis and Their Impacts on Pathogenic Bacteria. Microorganisms 2019, 7, 318. [Google Scholar] [CrossRef]
- Girma, A.; Aemiro, A. Antibacterial Activity of Lactic Acid Bacteria Isolated from Fermented Ethiopian Traditional Dairy Products against Food Spoilage and Pathogenic Bacterial Strains. J. Food Qual. 2021, 2021, 1–10. [Google Scholar] [CrossRef]
- Maurad, K.; Meriem, K.H. Probiotic Characteristics of Lactobacillus plantarum Strains from Traditional Butter Made from Camel Milk in Arid Regions (Sahara) of Algeria. Grasas Aceites 2008, 59, 218–224. [Google Scholar] [CrossRef]
- Heredia-Castro, P.Y.; Méndez-Romero, J.I.; Hernández-Mendoza, A.; Acedo-Félix, E.; González-Córdova, A.F.; Vallejo-Cordoba, B. Antimicrobial Activity and Partial Characterization of Bacteriocin-like Inhibitory Substances Produced by Lactobacillus Spp. Isolated from Artisanal Mexican Cheese. J. Dairy Sci. 2015, 98, 8285–8293. [Google Scholar] [CrossRef]
- Mezaini, A.; Bouras, A.D.; Chihib, N.; Nedjar-Arroume, N.; Hornez, J.P. Antibacterial Activity of Some Lactic Acid Bacteria Isolated from an Algerian Dairy Product. J. Environ. Public Health 2010, 2010, 1–6. [Google Scholar] [CrossRef]
- Hernandez, D.; Cardell, E.; Zarate, V. Antimicrobial Activity of Lactic Acid Bacteria Isolated from Tenerife Cheese: Initial Characterization of Plantaricin TF711, a Bacteriocin-like Substance Produced by Lactobacillus plantarum TF711. J. Appl. Microbiol. 2005, 99, 77–84. [Google Scholar] [CrossRef] [PubMed]
- Pinto, A.L.; Fernandes, M.; Pinto, C.; Albano, H.; Teixeira, P.; Castilho, F.; Gibbs, P.A. Partial Characterization of Bacteriocins Produced by Pediococcus pentosaceus and Enterococcus faecium Isolated from Ready-to-Eat Seafood. J. Biotechnol. 2007, 2, S220–S221. [Google Scholar] [CrossRef]
- Sourav, B.; Arijit, D. Study of Physical and Cultural Parameters on the Bacteriocins Produced by Lactic Acid Bacteria Isolated from Traditional Indian Fermented Foods. Am. J. Food Technol. 2010, 5, 111–120. [Google Scholar]
- Luo, F.; Feng, S.; Sun, Q.; Xiang, W.; Zhao, J.; Zhang, J.; Yang, Z. Screening for Bacteriocin-Producing Lactic Acid Bacteria from Kurut, a Traditional Naturally-Fermented Yak Milk from Qinghai–Tibet Plateau. Food Control 2011, 22, 50–53. [Google Scholar] [CrossRef]
- Simova, E.D.; Beshkova, D.B.; Dimitrov, Z.P. Characterization and Antimicrobial Spectrum of Bacteriocins Produced by Lactic Acid Bacteria Isolated from Traditional Bulgarian Dairy Products. J. Appl. Microbiol. 2009, 106, 692–701. [Google Scholar] [CrossRef]
- Khochamit, N.; Siripornadulsil, S.; Sukon, P.; Siripornadulsil, W. Antibacterial Activity and Genotypic–Phenotypic Characteristics of Bacteriocin-Producing Bacillus subtilis KKU213: Potential as a Probiotic Strain. Microbiol. Res. 2015, 170, 36–50. [Google Scholar] [CrossRef]
- Tomé, E.; Todorov, S.D.; Gibbs, P.A.; Teixeira, P.C. Partial Characterization of Nine Bacteriocins Produced by Lactic Acid Bacteria Isolated from Cold-Smoked Salmon with Activity against Listeria monocytogenes. Food Biotechnol. 2009, 23, 50–73. [Google Scholar] [CrossRef]
- Ignatova-Ivanova, T.; Ibryamova, S.; Bachvarova, D.; Salim, S.; Valkova, S.; Simeonova, Y.; Dimitrov, D.; Ivanov, R.; Chipev, N.; Natchev, N. Determination of the Antimicrobial Activity of Lactic Acid Bacteria Isolated from the Black Sea Mussel Mytilus galloprovincialis Lamarck, 1819. Pharmacia 2022, 69, 637–644. [Google Scholar] [CrossRef]
- Dejene, F.; Regasa Dadi, B.; Tadesse, D. In Vitro Antagonistic Effect of Lactic Acid Bacteria Isolated from Fermented Beverage and Finfish on Pathogenic and Foodborne Pathogenic Microorganism in Ethiopia. Int. J. Microbiol. 2021, 2021, 1–10. [Google Scholar] [CrossRef]
- Scatassa, M.L.; Gaglio, R.; Cardamone, C.; Macaluso, G.; Arcuri, L.; Todaro, M.; Mancuso, I. Anti-Listeria Activity of Lactic Acid Bacteria in Two Traditional Sicilian Cheeses. Ital. J. Food Saf. 2017, 6, 6191. [Google Scholar] [CrossRef] [PubMed]
- Bindu, A.; Lakshmidevi, N. Identification and in Vitro Evaluation of Probiotic Attributes of Lactic Acid Bacteria Isolated from Fermented Food Sources. Arch. Microbiol. 2021, 203, 579–595. [Google Scholar] [CrossRef] [PubMed]
- Xing, J.; Wang, G.; Zhang, Q.; Liu, X.; Gu, Z.; Zhang, H.; Chen, Y.Q.; Chen, W. Determining Antioxidant Activities of Lactobacilli Cell-Free Supernatants by Cellular Antioxidant Assay: A Comparison with Traditional Methods. PLoS ONE 2015, 10, e0119058. [Google Scholar] [CrossRef]
- Riane, K.; Sifour, M.; Ouled-Haddar, H.; Idoui, T.; Bounar, S.; Boussebt, S. Probiotic Properties and Antioxidant Efficiency of Lactobacillus plantarum 15 Isolated from Milk. J. Microbiol. Biotechnol. 2021, 9, 516–520. [Google Scholar] [CrossRef]
- Han, Q.; Kong, B.; Chen, Q.; Sun, F.; Zhang, H. In Vitro Comparison of Probiotic Properties of Lactic Acid Bacteria Isolated from Harbin Dry Sausages and Selected Probiotics. J. Funct. Foods. 2017, 32, 391–400. [Google Scholar] [CrossRef]
- Das, D.; Goyal, A. Antioxidant Activity and γ-Aminobutyric Acid (GABA) Producing Ability of Probiotic Lactobacillus plantarum DM5 Isolated from Marcha of Sikkim. LWT-Food Sci. Technol. 2015, 61, 263–268. [Google Scholar] [CrossRef]
- Feng, T.; Wang, J. Oxidative Stress Tolerance and Antioxidant Capacity of Lactic Acid Bacteria as Probiotic: A Systematic Review. Gut Microbes 2020, 12, 1801944. [Google Scholar] [CrossRef]
- Li, H.; Cao, Y. Lactic Acid Bacterial Cell Factories for Gamma-Aminobutyric Acid. Amino Acids 2010, 39, 1107–1116. [Google Scholar] [CrossRef] [PubMed]
- Amanda, C.d.M.; Cintia, R.R.C.; Jessica, F.; Irapuan, O.P.; Amanda, M.; Adelisa, A.F.; Eulalia, A.X. Activity of Metabolites Produced by New Strains of Lactobacillus in Modified de Man, Rogosa and Sharpe (MRS) Medium against Multidrug-Resistant Bacteria. Afr. J. Microbiol. Res. 2017, 11, 345–355. [Google Scholar] [CrossRef]
- Fuochi, V.; Coniglio, M.A.; Laghi, L.; Rescifina, A.; Caruso, M.; Stivala, A.; Furneri, P.M. Metabolic Characterization of Supernatants Produced by Lactobacillus Spp. With in Vitro Anti-Legionella Activity. Front. Microbiol. 2019, 10, 1403. [Google Scholar] [CrossRef]
- De Vuyst, L.; Leroy, F. Functional Role of Yeasts, Lactic Acid Bacteria and Acetic Acid Bacteria in Cocoa Fermentation Processes. FEMS Microbiol. Rev. 2020, 44, 432–453. [Google Scholar] [CrossRef]
- Wang, J.; Li, C.; Xue, J.; Yang, J.; Zhang, Q.; Zhang, H.; Chen, Y. Fermentation Characteristics and Angiotensin I-Converting Enzyme–Inhibitory Activity of Lactobacillus Helveticus Isolate H9 in Cow Milk, Soy Milk, and Mare Milk. J. Dairy Sci. 2015, 98, 3655–3664. [Google Scholar] [CrossRef] [PubMed]
- Garbowska, M.; Pluta, A.; Berthold-Pluta, A. Impact of Nisin-Producing Strains of Lactococcus lactis on the Contents of Bioactive Dipeptides, Free Amino Acids, and Biogenic Amines in Dutch-Type Cheese Models. Material 2020, 13, 1835. [Google Scholar] [CrossRef]
- Meng, D.; Sommella, E.; Salviati, E.; Campiglia, P.; Ganguli, K.; Djebali, K.; Zhu, W.; Walker, W.A. Indole-3-Lactic Acid, a Metabolite of Tryptophan, secreted by Bifidobacterium longum Subspecies Infantis Is Anti-Inflammatory in the Immature Intestine. Pediatr. Res. 2020, 88, 209–217. [Google Scholar] [CrossRef]
- Taniguchi, M.; Takao, Y.; Kawasaki, H.; Yamada, T.; Fukusaki, E. Profiling of Taste-Related Compounds during the Fermentation of Japanese Sake Brewed with or without a Traditional Seed Mash (Kimoto). J. Biosci. Bioeng. 2020, 130, 63–70. [Google Scholar] [CrossRef]
- Galli, V.; Venturi, M.; Mari, E.; Guerrini, S.; Granchi, L. Gamma-Aminobutyric Acid (GABA) Production in Fermented Milk by Lactic Acid Bacteria Isolated from Spontaneous Raw Milk Fermentation. Int. Dairy J. 2022, 127, 105284. [Google Scholar] [CrossRef]
- Khubber, S.; Marti-Quijal, F.J.; Tomasevic, I.; Remize, F.; Barba, F.J. Lactic Acid Fermentation as a Useful Strategy to Recover Antimicrobial and Antioxidant Compounds from Food and By-Products. Curr. Opin. Food Sci. 2022, 43, 189–198. [Google Scholar] [CrossRef]
- Kanklai, J.; Somwong, T.C.; Rungsirivanich, P.; Thongwai, N. Screening of GABA-Producing Lactic Acid Bacteria from Thai Fermented Foods and Probiotic Potential of Levilactobacillus brevis F064A for GABA-Fermented Mulberry Juice Production. Microorganisms 2020, 9, 33. [Google Scholar] [CrossRef] [PubMed]
- Chaudhary, A.; Verma, K.; Saharan, B.S. A GC-MS Based Metabolic Profiling of Probiotic Lactic Acid Bacteria Isolated from Traditional Food Products. J. Pure Appl. Microbiol. 2020, 14, 657–672. [Google Scholar] [CrossRef]
- Sánchez-López, F.; Robles-Olvera, V.J.; Hidalgo-Morales, M.; Tsopmo, A. Characterization of Amaranthus hypochondriacus Seed Protein Fractions, and Their Antioxidant Activity after Hydrolysis with Lactic Acid Bacteria. J. Cereal Sci. 2020, 95, 103075. [Google Scholar] [CrossRef]
- Muhialdin, B.J.; Marzlan, A.A.; Kadum, H.; Arulrajah, B.; Mohamad Asri, N.; Fathallah, S.; Meor Hussin, A.S. Metabolomics Profiling and Antimicrobial Activity of Fermented Date Fruit (Khastawi) Used as Functional Ingredients for Making Asian Confectionary (Dodol). Biotechnol. Biotechnol. Equip. 2021, 35, 478–486. [Google Scholar] [CrossRef]
- Qadi, W.S.M.; Mediani, A.; Benchoula, K.; Wong, E.H.; Misnan, N.M.; Sani, N.A. Characterization of Physicochemical, Biological, and Chemical Changes Associated with Coconut Milk Fermentation and Correlation Revealed by 1H NMR-Based Metabolomics. Foods 2023, 12, 1971. [Google Scholar] [CrossRef]

| Strain | B. cereus | B. subtilis | C. sakazakii | E. coli | S. aureus | S. Typhimurium |
|---|---|---|---|---|---|---|
| Zone of Inhibition (mm) | ||||||
| w3 | 17.00 ± 1.73 a | 20.00 ± 1.15 a | 12.00 ± 1.00 d | 15.32 ± 1.52 c | 16.00 ± 2.64 b | 16.00 ± 1.00 b |
| w6 | 16.66 ± 1.15 b | 18.31 ± 2.08 b | 14.32 ± 1.15 b | 16.60 ± 1.52 b | 21.62 ± 2.08 a | 14.00 ± 1.00 c |
| ng10 | 12.30 ± 0.57 d | 15.60 ± 2.64 c | 20.33 ± 1.15 a | 19.62 ± 1.15 a | 16.32 ± 2.3 b | 21.00 ± 1.73 a |
| ngue16 | 13.63 ± 1.52 c | 20.62 ± 0.57 a | 13.60 ± 1.52 c | 19.64 ± 2.51 a | 21.00 ± 2.64 a | 17.00 ±2.00 b |
| Strain | Intial pH | B. cereus | B. subtilis | C. sakazakii | E. coli | S. aureus | S. Typhimurium |
|---|---|---|---|---|---|---|---|
| Zone of Inhibition (mm) | |||||||
| w3 | 3.98 | 14.3 ± 0.57 a | 10.3± 0.57 a | 11.6 ± 1.52 a | 11.0 ± 0.40 a | 13.8 ± 0.8 a | 10.4 ± 0.96 a |
| w6 | 4.05 | 9.4 ± 0.51 b | 9.0 ± 0.00 a | 12.3 ± 0.57 b | 10.3 ± 1.15 a | 10.0 ± 0.00 b | 6.8 ± 0.60 b |
| ng10 | 4.19 | 7.5 ± 0.70 c | 14.6 ± 1.52 b | 15.8 ± 0.35 c | 11.4 ± 0.60 a | 12.4 ± 0.60 a | 8.8 ± 0.28 c |
| ngue16 | 4.10 | 11.2 ± 0.72 d | 10.6 ± 1.15 a | 9.7 ± 0.75 d | 10.6 ± 0.57 a | 14.3 ± 1.15 a | 14.4 ± 0.66 d |
| Strain | B. cereus | B. subtilis | C. sakazakii | E. coli | S. aureus | S. Typhimurium | ||||||
|---|---|---|---|---|---|---|---|---|---|---|---|---|
| MIC and MBC (mg/mL) | ||||||||||||
| MIC | MBC | MIC | MBC | MIC | MBC | MIC | MBC | MIC | MBC | MIC | MBC | |
| w3 | 6.25 | 12.50 | 6.25 | 12.50 | 6.25 | 12.50 | 3.12 | 6.25 | 6.25 | 12.50 | 6.25 | 12.50 |
| w6 | 12.50 | 25.00 | 6.25 | 12.50 | 3.12 | 12.50 | 6.25 | 12.50 | 3.12 | 6.25 | 6.25 | 12.50 |
| ng10 | 6.25 | 12.50 | 12.50 | 25.00 | 6.25 | 12.50 | 3.12 | 6.25 | 6.25 | 12.50 | 3.12 | 6.25 |
| ngue16 | 6.25 | 12.50 | 3.12 | 6.25 | 12.50 | 25.00 | 6.25 | 12.50 | 6.25 | 12.50 | 6.25 | 12.50 |
| Strain | pH | B. cereus | B. subtilis | C. sakazakii | E. coli | S. aureus | S. Typhimurium |
|---|---|---|---|---|---|---|---|
| Zone of Inhibition (mm) | |||||||
| w3 | 3 | 12.40 ± 0.52 Aa | 11.92 ± 0.36 Aa | 10.00 ± 0.40 Aa | 12.33 ± 0.57 Aa | 9.92 ± 0.25 Aa | 12.32 ± 0.57 Aa |
| 4 | 10.63 ± 0.52 Ab | 9.00 ± 1.00 Ab | 9.42 ± 0.75 Ab | 11.40 ± 0.55 Ab | 9.30 ± 0.70 Aa | 11.10 ± 0.8 Ab | |
| 6 | 7.66 ± 0.72 Ac | 6.60 ± 0.61 Ac | 7.80 ± 0.28 Ac | 8.22 ± 0.68 Ac | 7.54 ± 0.50 Ac | 9.00 ± 0.57 Ac | |
| 8 | 4.10 ± 0.28 Ad | 5.52 ± 0.5 Ad | 5.00 ± 0.45 Ad | 6.33 ± 0.57 Ad | 6.60 ± 0.57 Ad | 6.12 ± 0.36 Ad | |
| 9 | N.I | N.I | N.I | N.I | N.I | N.I | |
| w6 | 3 | 10.22 ± 0.34 Ba | 11.82 ± 0.60 Aa | 13.52 ± 0.92 Ba | 11.62 ± 1.15 Ba | 9.74 ± 0.40 Ab | 8.74 ± 0.68 Bb |
| 4 | 10.90 ± 1.00 Aa | 9.40 ± 0.51 Ab | 11.60 ± 0.57 Bb | 9.84 ± 0.76 Bb | 10.30 ± 1.15 Ba | 9.90 ± 0.7 Ba | |
| 6 | 8.64 ± 0.57 Bb | 8.62 ± 1.15 Bc | 8.50 ± 0.51 Bc | 8.60 ± 0.57 Ac | 9.32 ± 0.57 Bc | 7.62 ± 0.57 Bc | |
| 8 | 6.00 ± 0.50 Bc | 6.80 ± 0.76 Bd | 6.84 ± 0.28 Bd | 5.30 ± 0.57 Bd | 5.00 ± 0.00 Bd | 6.60 ± 0.30 Ad | |
| 9 | N.I | N.I | N.I | N.I | N.I | N.I | |
| ng10 | 3 | 9.00 ± 0.00 Ca | 11.60 ± 0.85 Ab | 13.62 ± 0.70 Ba | 10.92 ± 1.01 Ca | 9.62 ± 0.57 Aa | 10.82 ± 0.60 Ca |
| 4 | 8.51 ± 0.50 Bb | 13.52 ± 0.50 Ba | 12.80 ± 0.28 Cb | 9.00 ± 0.00 Bb | 8.50 ± 0.50 Cb | 8.61 ± 0.57 Cb | |
| 6 | 6.63 ± 0.57 Cc | 10.20 ± 0.68 Cc | 10.55 ± 0.51 Cc | 7.42 ± 0.52 Bc | 7.00 ± 0.00 Ac | 7.40 ± 0.50 Bc | |
| 8 | 5.10 ± 0.28 Cd | 6.32 ± 0.28 Bd | 5.63 ± 0.57 Ad | 6.00 ± 0.00 Ad | 5.62 ± 0.57 Bd | 5.62 ± 0.57 Bd | |
| 9 | N.I | N.I | N.I | N.I | N.I | N.I | |
| ngue16 | 3 | 9.82 ± 0.76 Ca | 11.32 ±0.57 Aa | 10.32 ± 0.57 Aa | 11.13 ± 0.57 Ba | 9.51 ± 0.51 Aa | 9.50 ± 0.50 Da |
| 4 | 8.94 ± 0.85 Bb | 9.62 ± 0.57 Ac | 9.31 ± 0.57 Ab | 10.80 ± 0.76 Cb | 9.32 ± 0.57 Aa | 9.70 ± 0.95 Ca | |
| 6 | 7.66 ± 0.57 Ac | 10.00 ± 1.00 Cb | 8.40 ± 0.51 Bc | 9.90 ± 0.40 Cc | 7.41 ± 0.52 Ab | 8.62 ± 0.69 Cb | |
| 8 | 5.00 ± 0.00 Cd | 5.82 ± 0.76 Ad | 5.32 ± 0.57 Ad | 7.00 ± 1.00 Cd | 6.50 ± 1.04 Ac | 6.30 ± 0.57 Ac | |
| 9 | N.I | N.I | N.I | N.I | N.I | N.I | |
| Strain | Temperature °C | B. cereus | B. subtilis | C. sakazakii | E. coli | S. aureus | S. Typhimurium |
|---|---|---|---|---|---|---|---|
| Zone of Inhibition (mm) | |||||||
| w3 | 60 | 13.10 ± 0.76 Aa | 13.32 ± 1.15 Aa | 13.22 ± 0.68 Aa | 10.00 ± 0.50 Aa | 9.62 ± 0.57 Aa | 12.00 ± 0.00 Aa |
| 80 | 9.60 ± 0.57 Ab | 12.30 ± 0.5 Ab | 10.80 ± 0.76 Ab | 10.33 ± 0.57 Ab | 10.34 ± 0.57 Aa | 11.62 ± 0.57 Ab | |
| 100 | 9.00 ± 1.00 Ab | 12.10 ± 0.36 Ab | 8.33 ± 1.15 Ac | 9.66 ±0.57 Ac | 9.80 ± 0.28 Aa | 10.30 ± 0.57 Ac | |
| 121 | N.I | N.I | N.I | N.I | N.I | N.I | |
| w6 | 60 | 11.63 ± 1.52 Ba | 11.32 ± 0.57 Ba | 11.66 ±0.57 Ba | 11.31 ± 1.15 Ba | 8.80 ± 0.23 Ba | 14.00 ±1.00 Ba |
| 80 | 10.60 ± 1.15 Bb | 9.50 ± 0.50 Bb | 10.14 ± 1.01 Ab | 10.00 ± 1.00 Ab | 7.60 ± 0.57 Bb | 10.64 ± 1.15 Bb | |
| 100 | 8.62 ± 0.57 Bc | 6.30 ± 0.57 Bc | 10.32 ± 0.57 Bb | 7.33 ± 0.57 Bc | 6.82 ± 0.76 Bc | 9.60 ± 0.52 Bc | |
| 121 | N.I | N.I | N.I | N.I | N.I | N.I | |
| ng10 | 60 | 10.64 ± 1.52 Ca | 12.90 ± 0.17 Aa | 12.15 ±1.04 Ba | 9.51 ± 0.86 Ca | 11.32 ± 1.15 Ca | 12.63 ± 0.57 Aa |
| 80 | 9.00 ± 1.00 Cb | 11.52 ± 1.3 Cb | 12.30 ± 0.57 Ba | 8.62 ± 0.57 Bb | 10.60 ± 0.57 Ab | 10.70 ± 0.68 Bb | |
| 100 | 9.40 ± 0.51 Ab | 10.55 ± 0.51 Cc | 9.62 ± 1.15 Cb | 8.80 ± 0.28 Cb | 10.30 ± 0.57 Cb | 10.10 ±0.40 Ab | |
| 121 | N.I | N.I | N.I | N.I | N.I | N.I | |
| ngue16 | 60 | 10.32 ± 1.52 Ca | 12.38 ± 0.57 Aa | 10.00 ± 0.00 Ca | 13.66 ± 0.57 Da | 10.63 ± 0.57 Da | 11.12 ± 0.28 Ca |
| 80 | 8.60 ± 0.57 Db | 11.72 ± 0.64 Ca | 10.34 ± 1.15 Ab | 11.32 ± 1.5 2 Cb | 11.32 ± 1.15 Cb | 11.33 ± 0.57 Aa | |
| 100 | 8.62 ± 0.57 Bb | 10.20 ± 0.34 Cb | 10.30 ± 0.57 Bb | 9.30 ± 0.57 Ac | 9.60 ± 0.57 Ac | 10.30 ± 0.57 Ab | |
| 121 | N.I | N.I | N.I | N.I | N.I | N.I | |
| Strain | B. cereus | B. subtilis | C. sakazakii | E. coli | S. aureus | S. Typhimurium |
|---|---|---|---|---|---|---|
| Zone of Inhibition (mm) | ||||||
| w3 | ||||||
| proteinase K | N.I | N.I | N.I | N.I | N.I | N.I |
| pepsin | N.I | N.I | N.I | N.I | N.I | N.I |
| catalase | 7.6 ± 0.57 a | 8.32 ± 1.15 a | 6.32 ± 0.57 a | 5.60 ± 0.57 a | 8.60 ± 0.57 a | 7.34 ± 1.15 a |
| w6 | ||||||
| proteinase K | N.I | N.I | N.I | N.I | N.I | N.I |
| pepsin | N.I | N.I | N.I | N.I | N.I | N.I |
| catalase | 7.6 ± 1.52 a | 7.00 ± 0.00 b | 6.82 ± 0.23 a | 6.66 ± 0.57 b | 6.22 ± 0.40 b | 8.00 ± 1.00 b |
| ng10 | ||||||
| proteinase K | N.I | N.I | N.I | N.I | N.I | N.I |
| pepsin | N.I | N.I | N.I | N.I | N.I | N.I |
| catalase | 6.3 ± 0.57 b | 7.3 ± 1.15 b | 8.60 ± 0.57 b | 7.00 ± 0.00 c | 6.64 ± 0.57 b | 6.60 ± 0.57 c |
| ngue16 | ||||||
| proteinase K | N.I | N.I | N.I | N.I | N.I | N.I |
| pepsin | N.I | N.I | N.I | N.I | N.I | N.I |
| catalase | 5.6 ± 0.57 c | 6.63 ± 0.57 c | 5.66 ± 0.57 c | 6.32 ± 1.15 b | 6.23 ± 0.46 b | 7.60 ± 1.15 a |
| Strains | DPPH % | FRAP (mmol TE/g) |
|---|---|---|
| w3 | 71.0 ± 2.64 a | 80.6 ± 3.05 a |
| w6 | 72.6 ± 2.51 a | 63.6 ± 3.51 b |
| ng10 | 79.3 ± 1.52 b | 64.0 ± 2.00 b |
| ngue16 | 76.5 ± 0.70 c | 69.6 ± 3.78 c |
| MRS broth | 33.0 ± 3.60 d | 10.4 ± 1.50 d |
| Metabolites | Characteristic Signals | MRS Broth | Cell-Free Supernatant |
|---|---|---|---|
| GABA | 0.98 | − | + |
| Acetic acid | 1.86 | − | + |
| Acetoin | 1.42, 2.22 | + | − |
| Format | 8.42 | − | + |
| Lactic acid | 1.3 | − | + |
| Pyruvate | 2.38 | + | − |
| Glucose | 3.9 | + | − |
| Sucrose | 5.22 | − | + |
| Fructose | 3.7 | + | − |
| Maltose | 3.82 | + | − |
| Ribose | 3.5 | + | − |
| Cysteine | 3.98 | + | − |
| Uracil | 5.79 | − | + |
| Uridine | 5.9 | − | + |
| Thymine | 7.34 | − | + |
| Tryptophane | 3.3 | + | − |
| Alanine | 1.5 | + | − |
| Asparagine | 2.98 | + | − |
| Isoleucine | 3.66 | + | − |
| 5-hydroxylysine | 3.78 | + | − |
| Guanidinosuccinic | 2.46 | + | − |
| Histamine | 7.26 | − | + |
| Galactonate | 3.74 | + | − |
| Xylose | 3.94 | + | − |
| 2-hydroxyvalerte | 1.26 | − | + |
| Propylene glycol | 1.14 | − | + |
| 3-aminoisobutyrate | 3.02 | + | − |
| Isopropanol | 1.18 | − | + |
| Isocitrate | 2.62 | + | − |
| Glutamine | 2.4, 6.9 | − | + |
| 2-phosphoglycerate | 3.94 | + | − |
| 4-carboxyglutamate | 2.34 | − | + |
| Anserine | 7.18, 8.34 | − | + |
| Valine | 3.58 | + | − |
| Betaine | 3.26 | + | − |
| Serine | 3.86 | − | + |
| Threonine | 1.34 | + | − |
| Trans-4-hydroxy-l-proline | 2.14, 3.42 | + | − |
| Glutamate | 2.1 | − | + |
| Allantoin | 6.05 | − | + |
| NADP+ | 6.1 | − | + |
| Histidine | 7.22 | − | + |
| Citrulline | 1.62 | + | − |
| Mannose | 5.18 | − | + |
| Glucuronate | 3.54 | + | − |
| Indol-3-lactate | 7.74 | − | + |
| 5.6- Dihydrothymine | 2.78 | + | − |
| Cellobiose | 3.34 | + | − |
| Arginine | 3.26 | + | − |
Disclaimer/Publisher’s Note: The statements, opinions and data contained in all publications are solely those of the individual author(s) and contributor(s) and not of MDPI and/or the editor(s). MDPI and/or the editor(s) disclaim responsibility for any injury to people or property resulting from any ideas, methods, instructions or products referred to in the content. |
© 2023 by the authors. Licensee MDPI, Basel, Switzerland. This article is an open access article distributed under the terms and conditions of the Creative Commons Attribution (CC BY) license (https://creativecommons.org/licenses/by/4.0/).
Share and Cite
Qadi, W.S.M.; Mediani, A.; Kasim, Z.M.; Misnan, N.M.; Sani, N.A.; Jamar, N.H. Biological Characterization and Metabolic Variations among Cell-Free Supernatants Produced by Selected Plant-Based Lactic Acid Bacteria. Metabolites 2023, 13, 849. https://doi.org/10.3390/metabo13070849
Qadi WSM, Mediani A, Kasim ZM, Misnan NM, Sani NA, Jamar NH. Biological Characterization and Metabolic Variations among Cell-Free Supernatants Produced by Selected Plant-Based Lactic Acid Bacteria. Metabolites. 2023; 13(7):849. https://doi.org/10.3390/metabo13070849
Chicago/Turabian StyleQadi, Wasim S. M., Ahmed Mediani, Zalifah Mohd Kasim, Norazlan Mohmad Misnan, Norrakiah Abdullah Sani, and Nur Hidayah Jamar. 2023. "Biological Characterization and Metabolic Variations among Cell-Free Supernatants Produced by Selected Plant-Based Lactic Acid Bacteria" Metabolites 13, no. 7: 849. https://doi.org/10.3390/metabo13070849
APA StyleQadi, W. S. M., Mediani, A., Kasim, Z. M., Misnan, N. M., Sani, N. A., & Jamar, N. H. (2023). Biological Characterization and Metabolic Variations among Cell-Free Supernatants Produced by Selected Plant-Based Lactic Acid Bacteria. Metabolites, 13(7), 849. https://doi.org/10.3390/metabo13070849

